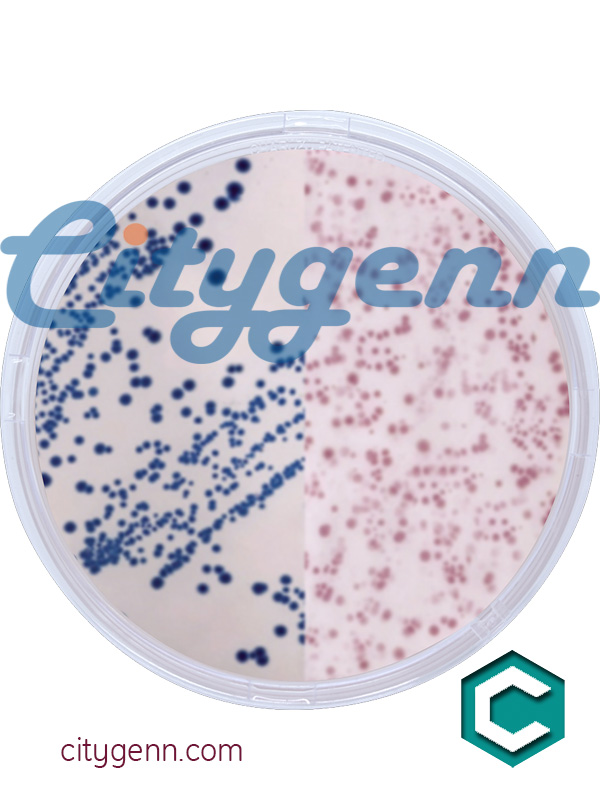

نام کالا :
محیط کشت مانیتول سالت فنول رد آگار کد 63567 سیگما آلدریچ
نام کالا انگلیسی :Mannitol Salt Phenol Red Agar suitable for microbiology, NutriSelect Basic
کد کالا :63567
کمپانی :میلیپور
وزن/جرم ملکولی :-
قیمت و دسترسی
شماره کاتالوگ | واحد کالا | قیمت | واحد | سفارش | |
63567-500G-F | 500G | تومان | |||
جهت آگاهی از قیمت کالا با کارشناسان ما تماس حاصل فرمایید | |||||
شرح و توضیحات
محیط کشت مانیتول سالت فنول رد آگار کد 63567 سیگما آلدریچ
Mannitol Salt Phenol Red Agar
suitable for microbiology, NutriSelect Basic
Synonym(s): Chapman Agar
Mannitol Salt Phenol Red Agar
suitable for microbiology, NutriSelect Basic
Synonym(s): Chapman Agar
مشخصات
sterility
non-sterile
Quality Level
form
powder
shelf life
limited shelf life, expiry date on the label
composition
agar, 15.0 g/L
D-mannitol, 10.0 g/L
meat extract, 1.0 g/L
peptone, 10.0 g/L
phenol red, 0.025 g/L
sodium chloride, 75.0 g/L
manufacturer/tradename
NutriSelect® Basic
technique(s)
microbiological culture: suitable
final pH
7.4±0.2 (25 °C)
application(s)
bioburden testing
clinical testing
environmental
food and beverages
veterinary
microbiology
suitability
nonselective and differential for Staphylococcus spp.
Storage Class Code
11 - Combustible Solids
WGK
WGK 3
Flash Point(F)
Not applicable
Flash Point(C)
Not applicable
Personal Protective Equipment
dust mask type N95 (US)
محصلات مشابه
-
محیط کشت مانیتول سالت فنول رد آگار کد 105404 مرک آلمان
GranuCult Mannitol salt phenol-red agar EP, USP, JP, suitable for microbiology
1.05404
نمایش قیمت
شماره کاتالوگ واحد کالا قیمت واحد سفارش 1.05404.0500 500G تومان